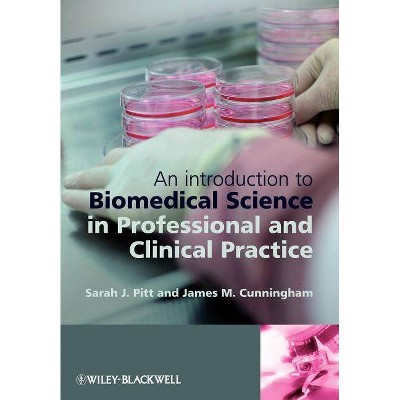
An Introduction to Biomedical Science in Professional and Clinical Practice - by  Sarah Jane Pitt & Jim Cunningham (Paperback)

Science, Theory and Clinical Application in Orthopaedic Manual Physical Therapy - by Ola Grimsby & Jim Rivard (Paperback)

Similar Products
Products of same category from the store
AllProduct info
<p/><br></br><p><b> Book Synopsis </b></p></br></br>This long awaited textbook, and its companion texts, from The Ola Grimsby Institute provide decades of clinical experience and reasoning, with both historical and current evidence, with rationale for active treatments in orthopaedic manual therapy. Practical guidelines for exercise rehabilitation are presented with this logical and exciting work. Incorporating experience and science, this book provides new approaches and treatment principles to make what you already do more effective. Extensive Content: Over 388 pages and 725 illustrations, photographs and tables Ola Grimsby and his co-authors have compiled a significant resource for the practicing physical therapist and manual therapist. Ideal for both the classroom and clinic.
Price History
Price Archive shows prices from various stores, lets you see history and find the cheapest. There is no actual sale on the website. For all support, inquiry and suggestion messages communication@pricearchive.us